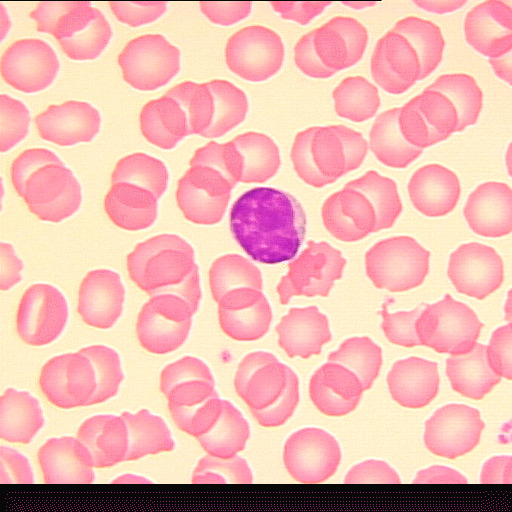
b5-8k9l.gif b5-8k9l.gif

Dublin Core
Title
Cavia porcellus
guinea pig or domestic guinea pig or cavy or domestic cavy / cochon d'Inde ou cobaye domestique ou cobaye commun ou cobaye
whole mount (EN) / montage entier (FR)
Description
Kingdom (EN) / Règne (FR) : Animalia / Animaux
Phylum (EN) / Embranchement (FR) : Chordata / Chordés
Class (EN) / Classe (FR) : Mammalia / Mammifères
Order (EN) / Ordre (FR) : Rodentia / Rodentiens
Species (EN) / Espèces (FR) : Cavia porcellus
(EN) : Small lymphocyte in guinea pig blood (Whole Mount, Wright's stain, x100, Slide B5.8k-9).
(FR) : Petit lymphocyte dans le sang d'un cochon d'Inde (Montage entier, coloration de Wright, x100, Lame B5.8k-9).
Format
photography (EN) / photographie (FR)
gif
Date
Image(s) : 1995-08-04
Source
Harris, Richard J.
Identifier
b5-8k9l.gif
Rights
Attribution: Cavia porcellus, https://omeka.uottawa.ca/biodidac/items/show/5234, BIODIDAC, CC BY-NC 4.0, https://creativecommons.org/licenses/by-nc/4.0